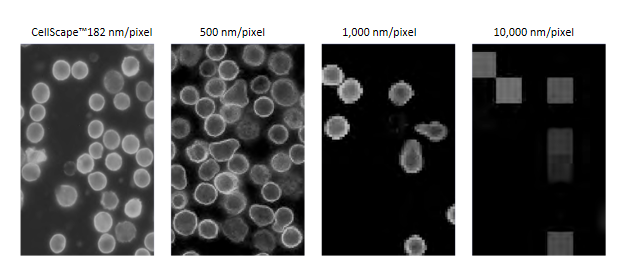
1648452776704497.png 图片6.png

2022.03.28
2022年3月,Canopy Biosciences正式宣布推出新一代微環境多靶標蛋白分析系統CellScape™,以推進原位空間表型定量分析這一前沿技術。
CellScape™保留了上一代微環境多靶標蛋白分析ZellScannerONE核心技術ChipCytometry的單細胞分辨率、超高動態範圍成像與超多重生物標誌物檢測等特點,同時集成了先進的高速成像技術、全自動化和多樣本自動處理技術的優勢,能更快速、更清晰地可視化樣本中生物標誌物的表達和空間分布,獲得更多深入的定量數據,將高通量空間蛋白組學的研究提升到了新的高度,使大規模臨床病理研究成為可能。

圖1. 新一代微環境多靶標蛋白分析系統CellScape™
牛津大學胃腸病學教授Paul Klenerman博士表示「ChipCytometry平臺是我們在人體組織樣本上進行深入的空間免疫分析時,開發高通量染色方法非常有用的一個工具。CellScape™在通量和自動化方面的改進,可以加快我們對改善患者護理的研究,因為它對擴大研究規模和探索更大的靶標群體提供了更好的機會。」
Canopy Biosciences公司產品經理Thomas Campbell博士補充:「Bruker於2020年收購Canopy Biosciences後,我們能夠利用Bruker先進的熒光顯微鏡專業技術將CellScape™設計為一個集成的、多路復用的成像系統,這個系統經過高度優化,可以廣泛適用於具有亞細胞分辨率的高通量定量空間組學的應用。CellScape™光學性能的改善建立在高分辨率和高動態範圍的基礎上,它目前是我們ChipCytometry同類技術中的明星產品。
CellScape™呈現更多優勢
用更少的時間,得到更多的細節和數據
(1)超高通量:在單個樣本上測量幾乎無限的生物標誌物
CellScape™ 的核心技術是Canopy公司專為空間組學分析研發的專利技術—ChipCytometry,它整合了創造性的樣品存儲技術、多重多通道檢測技術和基於圖像的單細胞分析方法,從根本上突破了傳統方法的各類局限,可以對樣本中的生物標誌物的表達和空間分布進行單細胞分辨率成像,同時獲得定量的數據,因此能為研究人員提供更多的信息以闡明疾病的發病機製,並幫助開發出更多新型療法。

圖2. ChipCytometry工作流程
ChipCytometry利用Photo-bleaching技術實現在同一樣本上進行多輪、序列式的染色和淬滅,理論上可以在單個樣本上測量幾乎無限種生物標誌物。在此過程中,熒光通道相互獨立,杜絕了傳統熒光串色交叉幹擾的影響。

圖3. 人非小細胞肺癌細胞13-plex染色分析
(2)自動化:用更少的時間,得到更多的細節和數據
CellScape™ 硬件包括自動液體處理和連續采集的4組樣本架,可每天24小時連續采集數據,如此高通量支持您從基礎研究擴展到轉化與臨床研究。

圖4. CellScape™ 多樣本自動化處理硬件
CellScape™獨有的光學系統提供的視野範圍是上一代儀器ZellScannerONE的兩倍,因此您可以在相同的時間內獲得兩倍的數據量,而且圖像分辨率更高。全新的FalconFAST™ 模式,甚至可以將視野範圍提高8倍,能夠更大地縮短實驗時間。

圖5. CellScape™與Zellscanner視野範圍對比
(3)精確成像:結合高分辨率和創新的高動態範圍,實現真正的單細胞定量
1、超高分辨率成像
其他空間生物學儀器的多細胞分辨率只有10,000 nm/pixel,而CellScape™ 的分辨率可達182 nm/pixel,更高的分辨率幫助您獲得更多至關重要的亞細胞層次信息。
圖6. CellScape™與其他空間生物學產品分辨率對比
2、獨特的高動態範圍成像可量化高表達和低表達目標
低表達只能通過長時間曝光來量化,但這會使明亮的細胞過度飽和。高表達可在較短的曝光時間內量化,但會丟失微弱信號。只有HDR多重曝光融合才能在相同的線性尺度上捕獲最暗的細胞和最亮的細胞。CellScape™獨特的高動態範圍(HDR)圖像采集方式可同時準確量化高表達和低表達目標。

圖7. CellScape™ HDR成像:乳腺癌細胞CD45RO染色
3、圖像可轉換為類流式分析數據
CellScape™可為細胞懸液和組織切片樣品提供精準的定量分析,將圖像數據轉換成定量的流式點圖,並對樣本中的每個細胞進行表型分析。

圖8. CellScape™ 類流式定量點圖
(4)兼容標準商用熒光標記抗體
通過開放性試劑和靈活的面板設計,您可以為任何免疫學、腫瘤學或神經生物學應用設計定製面板。
CellScape™可以廣泛應用於基礎科學研究、藥物開發和病理研究中:
1.臨床前和臨床生物標誌物開發
2.細胞和組織水平的生物標誌物檢測
3.免疫細胞分型和免疫監控
4.稀有細胞檢測和篩查
5.細胞水平的藥效動力學研究
6.揭示細胞群體的多樣性
7.腫瘤等復雜組織微環境描繪
如果您想對CellScape™技術有進一步了解,歡迎聯系我們。



